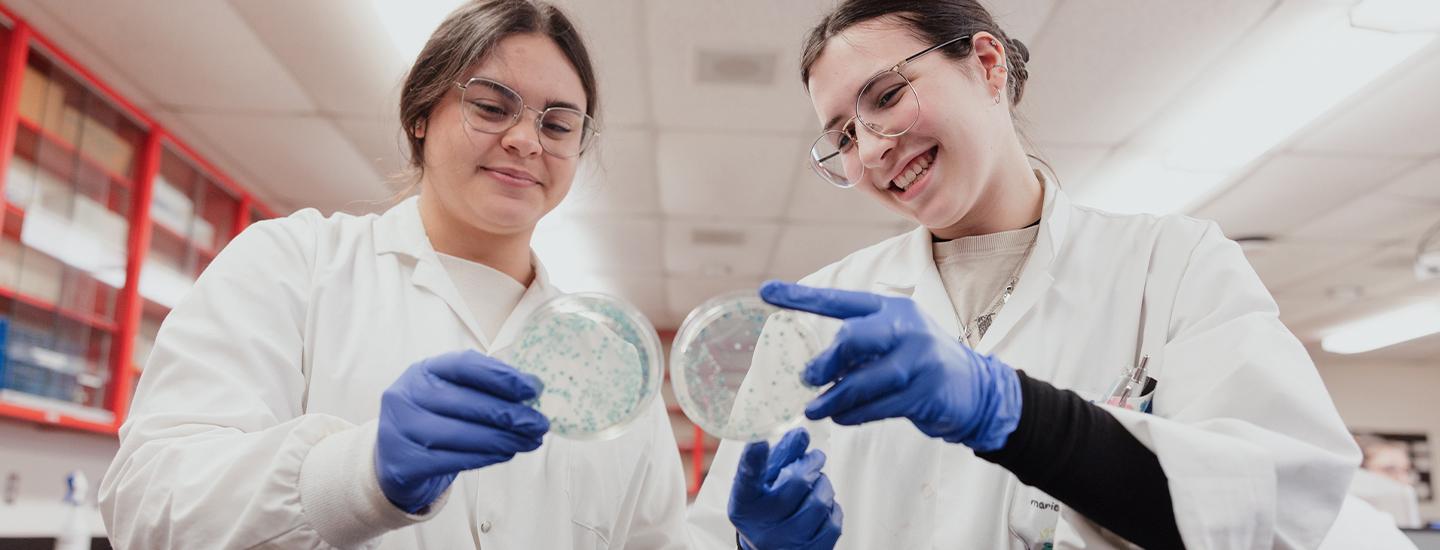
Biotechnologies 2 - Février 2026

Voici certains des mandats que nos finissants sont en mesure de remplir dans leur emploi :
- Réaliser des analyses biochimiques, microbiologiques, immunologiques et toxicologiques.
- Mener des activités liées au génie génétique, grâce à l’étude de l’ADN.
- Élaborer des produits agroalimentaires, tels que le vin, la bière et le fromage.
- Manipuler et identifier des micro-organismes et cultiver des cellules in vitro.
- Utiliser des bio-fermenteurs pour produire diverses molécules d’intérêt biologique.
- Tester des médicaments et des vaccins.
- Analyser l’eau et le sol pour contribuer à leur assainissement.
Ce programme me convient-il?
- Je possède des aptitudes pour les sciences, en particulier pour la biologie, la chimie et les mathématiques, en plus d’une curiosité pour l’expérimentation scientifique.
- J’ai une bonne dextérité manuelle et je suis une personne patiente.
- J’ai un sens de l’observation développé, un souci du détail, de la minutie et de la précision.
- J’aime travailler en équipe, mais je suis responsable et autonome.
- Je possède une bonne capacité d’analyse et de synthèse.
- Je me sens à l'aise de travailler avec des animaux et des substances biologiques (sang et bactéries).